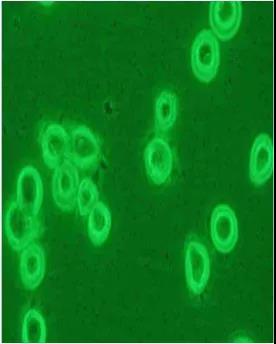
要开始培养细胞了！我们应该注意哪些事项？

8 年
手机商铺
技术资料/正文
351 人阅读发布时间:2020-03-06 09:02
开学了!大家又要开始养细胞了,然而细胞虐我千百遍,我待细胞如初恋!科研人是不会这么被轻易打败的。
想要养好细胞,这些关键点必须注意,希望能够帮助大家!
新买或惠赠的细胞
1.新买的或惠赠的细胞如何处理?
不管买的细胞、惠赠的细胞,刚拿到手应赶紧做这几件事:检测瓶子是否破裂;培养基是否漏出,是否浑浊;是否有支原体污染;迅速扩增冻存。
2.能否使用与原先培养条件不同的培养基?
不能。每一细胞株均有其特定使用且已适应的细胞培养基,若骤然使用和原先提供培养条件不同的培养基,细胞大都无法立即适应,造成细胞无法存活。
3.购买的细胞死亡或存活率不佳可能原因?
培养基使用错误或培养基品质不佳;血清使用错误或血清的品质不佳;解冻过程错误;冷冻细胞解冻后,加以洗涤细胞和离心;悬浮细胞误认为死细胞;培养温度使用错误;培养箱气体浓度达不到要求;细胞置于 –80 ℃ 太久。
复苏冻存的细胞
1.收到的冷冻管瓶身破裂,瓶盖有裂纹,或瓶盖脱落的原因?
冷冻管瓶盖裂纹,或瓶身破裂,可能是因为操作者夹取冷冻管时用力不当,造成冷冻管裂损,建议使用止血钳小心夹取。另冷冻管瓶盖松动或松脱,是因热胀冷缩的物理现象,冷冻管有可能因此而造成细胞污染,故冷冻管于放入和取出液氮桶时,均应立刻将冷冻管再一次扭紧。
2.冷冻管应如何解冻?
将冷冻管由液氮桶中取出解冻时,必须注意安全,可佩戴防护眼镜和手套预防冷冻管的爆裂。取出冷冻管后,须立即放入 37 ℃ 水浴环境中快速解冻,轻摇冷冻管使其在 1 分钟内全部融化,避免由于缓慢融化使水分渗入细胞内形成胞内再结晶对细胞造成损害。并注意水面不可超过冷冻管盖沿,否则易发生污染情形。
3.细胞冷冻管解冻培养时,是否应马上去除 DMSO?
现在大多数实验室会在解冻细胞后加培养液将DMSO除去,但也有研究者认为除少数特别注明对 DMSO 敏感的细胞外,绝大部分细胞株(包括悬浮性细胞),在解冻之后,可直接放入含有 10~15 ml 新鲜培养基的培养角瓶中,待隔天再置换新鲜培养基以去除 DMSO 即可,如此可避免大部分解冻后细胞无法生长或贴附的问题。

4.如何正确选择培养基种类?
引用几款比较经典的培养基举例:

5.如何选用特殊细胞系培养基?
培养某一类型细胞没有固定的培养条件。在 MEM 中培养的细胞,很可能在 DMEM 或 M199 中同样很容易生长。总之,首选 MEM 做粘附细胞培养,RPMI-1640 做悬浮细胞培养是一个好的开始。
6.什么培养基中可以省去加酚红?
酚红在培养基中被用来作为 PH 值的指示剂:中性时为红色,酸性时为黄色,碱性时为紫色。研究表明,酚红可以模拟固醇类激素的作用(特别是雌激素)。为避免固醇类反应,培养细胞,尤其是哺乳类细胞时,用不加酚红的培养基。由于酚红干扰检测,一些研究人员在做流式细胞检测时,不使用加有酚红的培养基。
7.细胞培养基的配制和储存应该注意什么?
细胞培养基配好后,要先抽取少许放入培养瓶内在37℃培养箱内放置24~48h,已检测培养液是否有污染,然后方可用于实验。配置培养基所需的血清要合格并且保持稳定。一个批号试用效果良好后,就可一次购入较多同一批号的血清,这样实验条件稳定,配液时调整pH值较容易。每次配液量以使用两周左右的量为宜,一次配液不要太多,一是短期内用不完造成营养成分损失需要补充,二是量大易造成污染。
8.为何培养基保存于 4 ℃ 冰箱中,颜色会偏紫色?
培养基保存于 4 ℃ 冰箱中,培养基内的 CO2 会逐渐溢出,造成培养基越来越偏碱性,而培养基中的酸碱指示剂 (通常为 phenol red) 的颜色也会随碱性增加而更偏紫色。培养基偏碱的结果, 将造成细胞生长停滞或死亡。若培养基偏碱时,可以通入无菌过滤 CO2,以调整 pH 值。
9.什么情况下用到无血清培养基?
对于应用培养细胞进行分离制备细胞生长因子、单克隆抗体等应该选择无血清培养基。
10.如何选择正确的血清种类?

11.可否使用与原先培养条件不同的血清种类?
不能。血清是细胞培养上一个极为重要的营养来源,所以血清的种类和品质对于细胞的生长会产生极大的影响。来自不同物种的血清,在一些物质或分子的量或内容物上都有所不同,血清使用错误常会造成细胞无法存活。
12.血清灭活是否必须?
一般情况下不建议。热灭活是以 56℃,30 分钟来处理已解冻的血清,因为此加热步骤,可以使补体去活化,而补体所参与的反应有:溶细胞活性,平滑肌的收缩,肥大细胞和血小板组胺的释放,增强吞噬作用,淋巴细胞、巨噬细胞的趋化和激活。
实验显示,经过正确处理的热灭活血清,对大多数的细胞而言是不需要的。经此处理过的血清对细胞的生长只有微小的促进,或完全没有任何作用,甚至通常因为高温处理影响了血清的质量,而造成细胞生长速率的降低。而经过热处理的血清,沉淀物的形成会显著的增多, 这些沉淀物在倒立显微镜下观察,像是 "小黑点",常常会让研究者 误以为是血清遭受污染,而把血清放在 37C 环境中,又会使此沉淀 物更增多,使研究者误认为是微生物的分裂扩增。因此除了做免疫学相关实验和培养一些特定细胞,如平滑肌细胞、胚胎干细胞等,不需要做热灭活处理。
13.培养基中是否添加抗生素?
除特殊筛选系统中外,一般正常培养状态下,培养基中不应添加任何抗生素。
14.何时更换培养基?
视细胞生长密度而定,或遵照细胞株基本数据上的更换时间,按时更换培养基即可。
细胞传代
1.细胞传代的方法都有哪些?
根据不同的细胞采取不同的方法。贴壁生长的细胞用消化法传代;部分贴壁生长的细胞用直接吹打即可传代;悬浮生长的细胞可以采用直接吹打或离心分离后传代,或用自然沉降法吸除上清后,再吹打。
2.原代培养的首次传代应注意的问题?
细胞没有生长到足以覆盖瓶底壁的大部分表面以前,不要急于传代;原代培养时细胞多为混杂生长,不同的细胞有不同的消化时间,因此要根据需要注意观察及时处理,并根据不同细胞对胰蛋白酶的耐受时间而分离和纯化所需要的细胞;
吹打细胞时动作要轻巧尽可能减少对细胞的损伤;首次传代时细胞接种数量要多一些,使细胞能尽快适应新环境而利于细胞生存和增值;随消化分离而脱落的组织块也可一并传入新的培养瓶。
3.使用胰蛋白酶时加入EDTA的目的?应如何处理?
EDTA作用较胰蛋白酶缓和,主要作用在于能从组织生存环境中吸取Ca2+、Mg2+,这些离子是维持组织完整的重要因素。但EDTA单独使用不能使细胞完全分散,因而常与胰蛋白酶按不同比例混合使用,效果较好。常用比例为1:1或者2份EDTA:1份胰蛋白酶。EDTA的工作液浓度为0.02%,用不含Ca2+、Mg2+的BSS配置。如果使用EDTA,在终止消化前,需用缓冲液将消化液清除后才能加培养液。第一次开瓶后应立即少量分装于无菌试管中,保存于 –20 ℃,避免反复冷冻解冻造成胰蛋白酶的活性降低,并可减少污染的机会。
4.欲将一般动物细胞离心下来,其离心速率应为多少转速?
欲回收动物细胞,其离心速率一般为800~1000 rpm,5~10 分钟,过高的转速,将造成细胞死亡。
5.细胞的接种密度为何?
依照细胞株基本数据上的接种密度或稀释分盘的比例接种即可。细胞数太少或稀释的太多亦是造成细胞无法生长的重要原因之一。
6.细胞交叉污染的可能原因?
多种细胞系进行维持传代操作时,各细胞系所需的器材和溶液没有严格分开,往往会使一种细胞被另一种细胞污染。
细胞冻存
1.冷冻培养基为什么要加DMSO?
因为细胞在不加任何保护剂的情况下直接冻存时,细胞内外的水分都会很快形成冰晶,冰晶的形成将造成细胞损伤,还可引起细胞的的死亡。目前多采用甘油和DMSO做保护剂。这两种细胞无明显毒性,分子量小,溶解度大,易穿透细胞,可以使冰点下降,提高包膜对水的通透性。
2.DMSO 的等级和无菌过滤的方式为何?
冷冻保存使用的 DMSO 等级,必须为 Tissue culture grade 的 DMSO,其本身即为无菌状况,第一次开瓶后应立即少量分装于无菌试管中,保存于 4 ℃,避免反复冷冻解冻造成 DMSO 的裂解而释出有害物质,并可减少污染的机会。若要过滤 DMSO,则须使用耐 DMSO 的 Nylon 材质滤膜。
3.欲冷冻保存时,细胞冷冻管内应有多少细胞浓度?
冷冻管内细胞数目一般为 1x106 cells/ml vial,融合瘤细胞则以 5x106 cells/ml vial 为宜。
4.冷冻保存细胞的方法?
冷冻保存方法一:冷冻管置于 4 ℃ 30~60 分钟 →-20 ℃ 30 分钟 → -80 ℃ 16~18 小时(或隔夜) → 液氮槽 vapor phase 长期储存。
冷冻保存方法二:冷冻管置于已设定程序的可程序降温机中每分钟降 1~3 ℃ 至 –80 ℃ 以下, 再放入液氮槽 vapor phase 长期储存。–20 ℃ 不可超过 1 小时,以防止冰晶过大,造成细胞大量死亡,亦可跳过此步骤直接放入 –80 ℃ 冰箱中,存活率稍微降低一些。
5.细胞冻存太多会不会浪费?
每一种细胞系都应有充足的冻存储备,防止由于细胞污染等因素造成的细胞系的绝种,而且每一批次培养的细胞状态都不同,应该挑选几个状态较好的批次冻存保种。另外二倍体细胞等有限细胞系如果暂时不用最好冻存以免传代太多,造成细胞衰老或者发生改变。
6.如何识别和预防常见的细胞污染?
细菌污染:细菌是一种原核细胞微生物,其大小以微米(μm)计。常见的污染细菌有革兰氏阴性菌和大肠杆菌、假单胞菌等,革兰氏阴性菌中白色葡萄球菌等比较常见。
一旦发生细菌污染较易发现,多数情况下培养液短期内颜色变黄,表明有大量酸性物质产生,出现明显混浊现象;有时静置的培养液液体初看不混浊,但稍加振荡,就有很多混浊物漂起。倒置显微镜下观察,可见培养液中有大量圆球状颗粒漂浮。必要时可取少量培养液涂片染色检查以证实细菌种类;有的培养液改变不明显而又疑有污染,可取出少量培养液用普通肉汤接种或用未加双抗药物的培养液接种,也可取10ml细胞悬液以100rpm离心5min,沉淀中加入无抗生素的培养液2ml,置于37℃培养,24h可得结果。污染后细胞发生病理改变,胞内颗粒增多、增粗,最后变圆脱落死亡,造成试验失败和细胞株(系)丢失。

看到这种,别犹豫了你的细胞被污染了,那么怎么办呢,基本原则立马扔掉,别扩大污染,如果你的细胞真的十分宝贵,先用带有双抗的PBS反复冲洗几遍,然后再培养液中加入硫酸庆大霉素、新霉素(50ug/ml)等,培养3天后换成带有双抗的培养液培养。
真菌污染:是细胞培养过程中最常见的一种,尤其在梅雨季节进行细胞培养更易污染。污染培养细胞的多为烟曲霉、黑曲霉、毛霉菌、孢子霉、白念珠菌、酵母菌等。霉菌污染后多数在培养液中形成白色或浅黄色漂浮物。一般肉眼可见,较易被发现,短期内培养液多不混浊,倒置显微镜下可见于细胞之间纵横交错穿行的丝状、管状、及树枝状菌丝,并悬浮飘荡在培养液中。很多菌丝在高倍镜可见到有链状排列的菌珠;念珠菌或酵母菌形态呈卵形,散在细胞周边和细胞之间生长。镜下看时,要将培养瓶用酒精棉球擦干净,以防止与瓶外尤其瓶底外面生长的菌丝相混淆。真菌污染后,细胞生长变慢,但最后由于营养耗尽及毒性作用而使细胞脱落死亡。

真菌污染真的不建议处理,因为孢子容易飘散,可能这瓶没9过来,又扩大了污染,建议预防为主,在培养箱的水中加入硫酸铜,就是蓝色的那种东西。哎,如果你非救不可,可以采用两性霉素B(0.25-2.5),三天后换液加入含PS的培养液。
支原体污染:支原体是一种大小介于细菌和病毒之间(最小直径0.2um)并独立生活的微生物。约有1%可通过滤菌器。支原体无细胞壁形态呈高度多形性。可为圆形、丝状或梨形。
支原体形态多变,在光境下不易看清内部结构。电镜下观察支原体膜为三层结构。其中央有电干密度大的密集颗粒群或丝状的中心束。支原体多吸附或散在于细胞表面和细胞之间。横断面与细胞微绒毛相似,但微绒毛电子密度比支原体小,且中央无颗粒群或中央束。
支原体污染细胞后,培养液可不发生混浊。多数情况下细胞病理变化轻微或不显著,细微变化也可由于传代、换液而缓解,因此易被忽视。但个别严重者,可致细胞增殖缓慢,甚至从培养器皿脱落。

如果怀疑细胞被支原体污染可使用支原体检测试剂盒进行检测,如果确定是支原体污染可以选择支原体去除试剂进行处理。